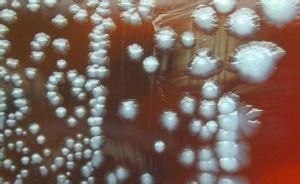
居泥桿菌屬

概述
居泥桿菌屬拉丁學名(Pelobacter Schink and Pfennig,1982) 直桿或微彎桿,0.5~0.8μm寬, 1.2~6.0 μm長,端圓或稍尖,單生、成對或短鏈。不產芽孢。有些種運動。最適生長溫度為33~35℃。最適pH 5.3~7.2。可利用的底物範圍窄,如鄰苯三酚、2,3-丁二醇、乙二醇、聚乙烯醇、乙醯乙烯、3-羥基丁酮、丙酮酸和乳酸。培養基中必須含還原劑,海洋種培養時要求 1%NaCl。發現於缺氧的海水泥土或淡水泥土。 DNA的G+C mol%是51.8。
居泥桿菌屬
居泥桿菌屬模式種
沒食子酸居泥桿菌(Pelobacter acidigallici)。種的鑑別特徵列於表6-17。細菌--腸桿菌
